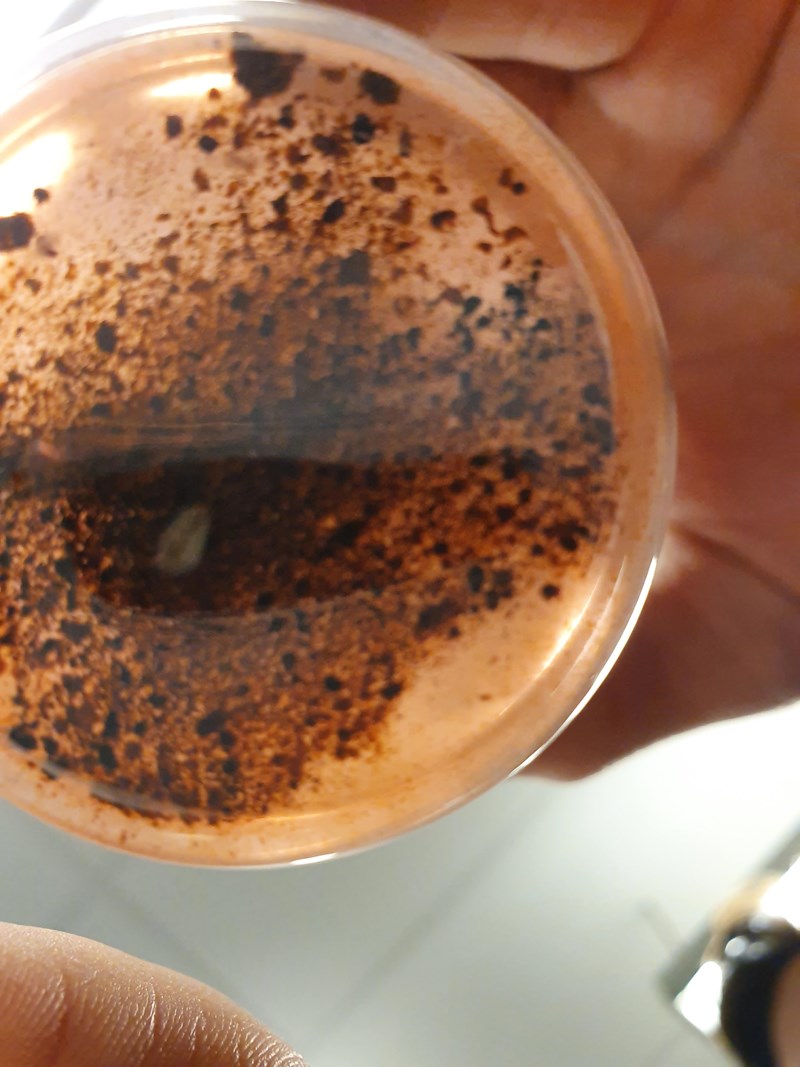

Laboration gällande korrosion
Hej, jag genomförde nyligen en labb i syfte att förstå korrosion av metaller, i detta fallet järn. I experimentet utsattes en järnskruv för Klorin (NaClO(aq)) för att testa ämnets duglighet som propplösare. Däremot så har jag svårt att formulera mig i diskussions avsnittet kring exakt vad som hänt, ex reaktions formler. Tyvärr räcker inte mina kunskaper till och jag har inte hittat någon relevant information på internet.
Tacksam för svar!
(Nedan finns ett utdrag från labbrapporten kring utförandet och det finns även möjlighet att bifoga bilder om det krävs.)
Materiel och metod
· 2 st 80 ml bägare
· 2 st gipsskruvar (2,9x51mm)
· 40 ml Klorin
· Mätglas
Lägg båda skruvarna på positionerade på samma sätt med huvudet uppåtvänt. Med mätglas mät 40 ml Klorin och tillsätt till en av bägarna. Ställ den Klorin fyllda bägaren samt kontrollen på samma plats, undangömt från solen. Observera förändringen vid regelbundna intervaller (ex. 3 dagar) och notera dessa.
Är du med på att hypokloritjonen (ClO-) är ett oxidationsmedel? Kloret har ett högt oxidationstal på +I vilket gör att det är väldigt benäget att ta upp elektroner. Det kan antingen reduceras till klorgas eller till kloridjoner beroende på förutsättningarna.
Vad tror du att det bruna materialet består av? Vad har i så fall hänt med järnet?
Sen är det något oklart vad det här har att göra med huruvida klorin är en bra propplösare eller inte.
Är röret med proppen i av järn kan jag förstå at det skulle spela roll, annars inte.